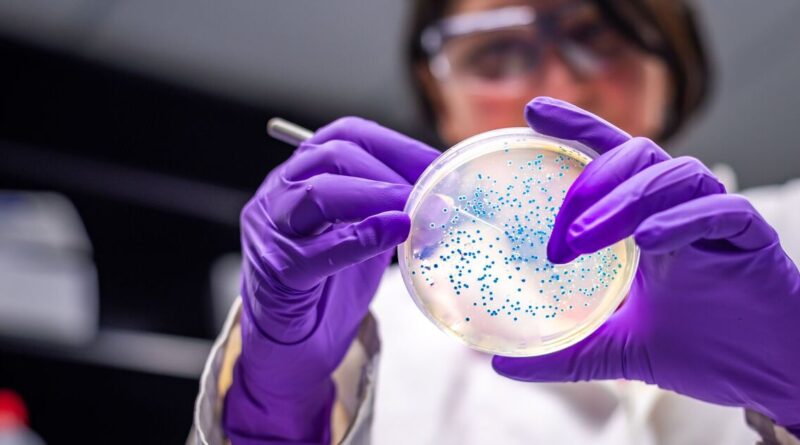

Superbug fears explode as ice cave bacteria discovered resistant to 10 antibiotics | World | News

5,000-year-old bacteria discovered in a Romanian cave are resistant to 10 modern antibiotics (Image: Getty)
Scientists have discovered ancient bacteria resistant to almost a dozen modern antibiotics, sparking fears of a new superbug. For the past 5,000 years, the bacteria, called Psychrobacter SC65A.3 – had been trapped under a thick layer of ice in the Scărişoara Cave, northwest Romania.
Romanian researchers have analysed the strain’s antibiotic resistance profile after drilling an 82-foot ice core representing a 13,000-year timeline. When they tested it against 28 antibiotics, the bacteria were resistant to 10, including medicines we currently use to treat infections of the lungs, skin, blood, reproductive system and urinary tract.
This is despite the fact that the organisms have existed for millennia before the invention of these vital medicines. The scientists also discovered that Psychrobacter harboured more than 100 resistance-related genes, according to the study published in Frontiers in Microbiology.
READ MORE: World’s next superbug is already spreading among us
READ MORE: Victorian superbug cases in England mapped as drug-resistant strain sparks fear

The antibiotic resistant bacteria was found in the Scărişoara cave in Transylvania, Romania (Image: Getty)
SC65A.3 is the first Psychrobacter strain for which resistance to certain antibiotics – including trimethoprim, clindamycin and metronidazole – has been reported, medicines currently used to treat diseases including tuberculosis (TB), colitis and UTIs.
“We commonly associate antibiotic resistance with misuse of antibiotics in urban and agricultural contexts, but antibiotic resistance is part of the natural evolution of the first occupants of our biosphere,” Dr Franklin Nobrega, Associate Professor at the University of Southampton, told the Express. “If we think that most habitats on our planet are cold-weather environments, cold-adapted organisms have been important in developing the ecologically rich environment we all live in today.
“In this adaptation battle, microorganisms have developed metabolic circuits, as antibiotic-resistant proteins, wired to protect their populations against naturally occurring antibiotics. Bacteria face daily battles with other bacteria in their habitats, competing for nutrients. While some develop naturally occurring antibiotics, others developed countermeasures (these antibiotic resistance genes) to survive these attacks.”
*** Ensure our latest news headlines always appear at the top of your Google Search by making us a Preferred Source. Click here to activate or add us as Preferred Source in your Google search settings. ***

The threat of global warming is a concerning factor in antimicrobial resistance (AMR) (Image: Getty)
The threat of global warming is a concerning factor in antimicrobial resistance (AMR), Dr Nobrega warned: “With global warming because of climate change, these cold environments will no longer trap these bacteria in these environments. Instead, they will be provided with an environment that allows them to thrive, becoming major players in our planet’s soil and aquatic microbiomes.
“AMR will impact simple medical procedures, such as going to the dentist. What we consider now a small risk, may be a deadly procedure if we don’t find alternatives and act on socioeconomic drivers of AMR.”
That said, the discovery of this antibiotic-resistant bacteria could still be a positive for humanity.

Dr Nobrega noted the biotechnological potential of these strains, describing cold-adapted microorganisms as ‘gifts for society’ (Image: Getty)
According to the researchers, Psychrobacter SC65A.3 also had nearly 600 genes with unknown functions, suggesting a yet untapped source for discovering new biological mechanisms, as well as 11 genes that could kill or stop the growth of other microbes. It could also be key to understanding how resistance naturally evolves and spreads.
“Understanding the emergence and spread of resistance is critical to block and design new treatment strategies in the rise of this silent pandemic,” Dr Nobrega explained, while noting the biotechnological potential of these strains.
“Cold-adapted microorganisms also contain gifts for society. Repurposing the tools that allow them to survive in the cold can help develop efficient industrial processes – eco-friendly processing – help us achieve Net Zero faster, and stop the rise of AMR due to climate change.”